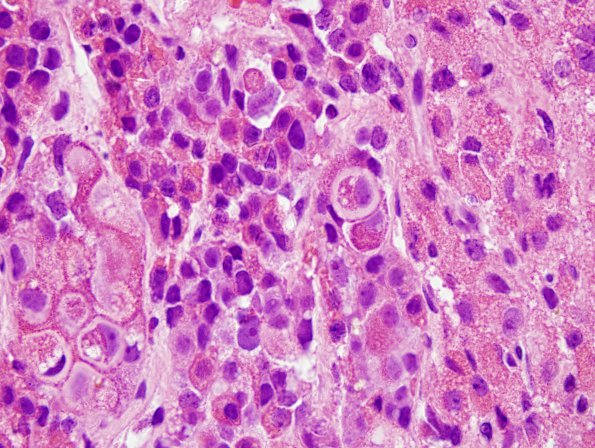
13A7 PA, ACTH, CR (Case 13) H&E 11

Table of Contents
Washington University Experience | NEOPLASM (SELLAR) | Pituitary Adenoma - Pituitary Neuroendocrine Neoplasm | Corticotroph | 13A7 PA, ACTH, CR (Case 13) H&E 11
Higher magnification of the non-neoplastic acini with prominent Crooke’s change. (H&E)